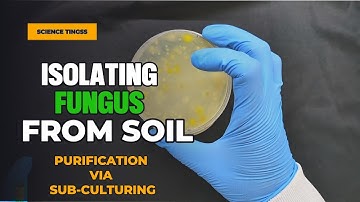
Hunting for soil microbes: The colourful world of #Trichoderma @sciencetingss
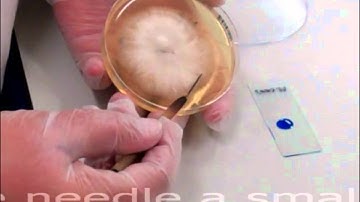
Microbiology: Lactophenol Cotton Blue Technique

⬇ DOWNLOAD NOW
Kalau muncul iklan pop-up, tutup lalu klik tombol kembali
Download lagu Trichoderma culture and Microscopic observation secara gratis hanya untuk keperluan promosi. Dukung artis favorit kamu dengan membeli musik original di iTunes atau platform resmi lainnya.
 Trichoderma Mold Fungi Timelapse
Trichoderma Mold Fungi Timelapse
Hunting for soil microbes: The colourful world of #Trichoderma @sciencetingss
Hunting for soil microbes: The colourful world of #Trichoderma @sciencetingss
Microbiology: Lactophenol Cotton Blue Technique
Microbiology: Lactophenol Cotton Blue Technique
 Vinegar VS Bacteria under the microscope!
Vinegar VS Bacteria under the microscope!
 Trichoderma - A brief over view. Information from a study on trichoderma.
Trichoderma - A brief over view. Information from a study on trichoderma.
 Trichoderma Viride Growth - #Day2 Fascinating Fungal Development 🌱
Trichoderma Viride Growth - #Day2 Fascinating Fungal Development 🌱
 How to produce Trichoderma ?! Learn with us
How to produce Trichoderma ?! Learn with us
 Trichomonas vaginalis in the urine #laboratory #mls #medtechstudent #microscope #microbiology #cls
Trichomonas vaginalis in the urine #laboratory #mls #medtechstudent #microscope #microbiology #cls